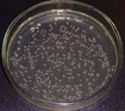
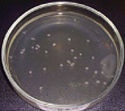

CORE_REFERENCE // ARTICLE_VIEW
¿Qué es la vida?
lang: eslectura: 3 minactualizado: 2025.08.20
El agua es la base de toda la vida en la tierra. Cada parte del cuerpo depende del agua. Las funciones de nuestras glándulas y órganos eventualmente se deteriorarán si no son nutridos con agua buena y limpia. El agua es un excelente solvente y la asimilación de nutrientes vitales y proteínas ocurre a través de la absorción de agua. El metabolismo, la digestión, el flujo sanguíneo y la reproducción celular dependen del suministro adecuado de agua.
Si tu cuerpo no está adecuadamente hidratado, las células extraerán agua de tu torrente sanguíneo, lo que hace que tu corazón trabaje más duro.
Mientras tanto, tus riñones no pueden purificar adecuadamente tu sangre, y cuando eso sucede, parte de la carga de trabajo de los riñones se transfiere al hígado y otros órganos, lo que puede causarles un estrés severo. Además, puedes desarrollar una serie de condiciones de salud menores como estreñimiento, piel seca y con picazón, acné, hemorragias nasales, infección del tracto urinario, tos, estornudos, presión sinusal y dolores de cabeza.
Así, el agua limpia es esencial para la salud. El agua que bebemos debe ser metabólicamente reestructurada antes de que esté bio-disponible para nuestro cuerpo. El Activador de Agua MRET lo hace por nosotros.
Activador de Agua MRET
El Agua Activada MRET es producida con la ayuda de la Tecnología de Efecto de Resonancia Molecular patentada en EE. UU. por Igor Smirnov, Ph.D. (Patente de EE. UU. No. 6022479). El activador de agua MRET es la fuente estacionaria de campo electromagnético resonante sutil, de baja frecuencia, con estructura compuesta. El Agua Activada MRET con la estructura molecular modificada, características físicas y electrodinámicas puede mejorar mecanismos moleculares específicos en células vivas.
INVESTIGACIONES EN MODELOS ANIMALES confirmaron: El agua MRET hidrata las estructuras celulares en el cuerpo, mejora el intercambio de agua intracelular/extracelular y la homeostasis; también aumenta sustancialmente los principales factores de resistencia celular natural a infecciones e inflamaciones como la fagocitosis (engullendo células extrañas) y respuesta inmune.
Investigación Oncológica en 500 ratones: El agua MRET aumentó la esperanza de vida en 61% e inhibió el crecimiento del tumor en 76% (3 semanas de prueba).
Investigación de Infección Estafilocócica en 400 ratones: 0% de tasa de mortalidad con agua MRET versus 30% de tasa de mortalidad con agua regular (9 días de prueba).
INVESTIGACIONES CIENTÍFICAS IN VITRO confirmaron: El agua MRET inhibe significativamente el crecimiento de bacterias, virus y células mutadas.
![]() |
![]() |
![]() |
| Control | tact = 30 min | tact = 60 min |
El efecto de la activación MRET en la inhibición del crecimiento del cultivo de Staphylococcus aureus
tact = 60 min tact = 30 min Control
El efecto del agua MRET en el crecimiento del tejido callus (células mutadas de origen botánico)
La presentación del agua MRET fue reconocida en el Simposio de la Universidad Rutgers sobre Asentamientos Lunares que tiene afiliación con la NASA y el Instituto Americano de Aeronáutica y Astronáutica.
![]() |
3-8 de junio de 2007 New Brunswick, NJ, EE. UU. _________________________________________________________________________ «Agua Activada MRET y su Aplicación Exitosa para Prevención, Tratamiento y Resistencia Mejorada a Tumores en Modelos Animales» Igor Smirnov, Ph.D., Global Quantech, Inc. |